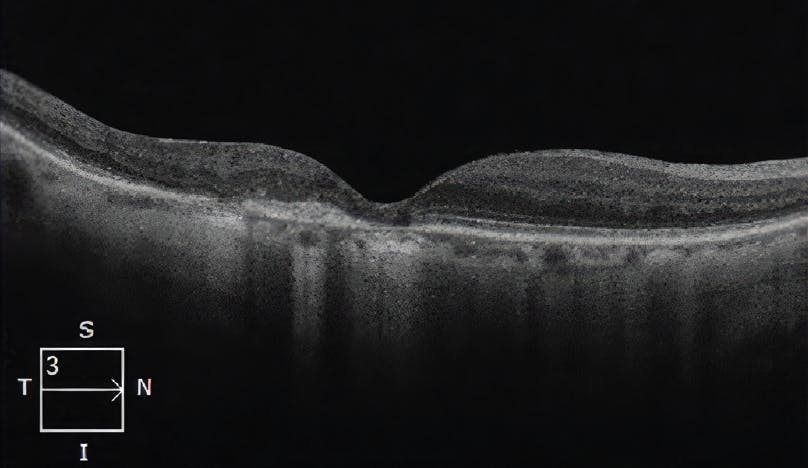
<p><strong>Figure 5. SD-OCT findings 3 years after PDT with VISUDYNE and after initiation of intravitreal aflibercept injections every 3 months.</strong> SD-OCT shows continuation of fully resolved edema and no cysts.</p>

Age-related macular degeneration (AMD) is the most common cause of vision loss with a high risk of blinding complications.1 AMD is most commonly observed in patients greater than 50 years of age and is characterized by deterioration of macular structure and function.1 In neovascular AMD, choroidal neovascularization (CNV) results in vascular leakage, hemorrhage, and fibrosis, which are the primary causes of vision loss in AMD.1
CNV in neovascular AMD can be classified on the basis of patterns of fluorescence on fluorescein angiography (FA). The predominantly classic form of CNV is readily identified by early hyperfluorescence with late severe and profuse leakage.1 Notably, in some patients, predominantly classic CNV can present as polypoidal choroidal vasculopathy (PCV), an important subtype of neovascularization defined by a branching vascular network and nodular aneurysmal neovascular dilations (polypoidal lesions).1 On FA, PCV is characterized usually by occult hyperfluorescence with initial stippled hyperfluorescence over an area of elevated retinal pigment epithelium (RPE) that slowly expands over time during the FA.1 However, PCV morphology can be better characterized using indocyanine green angiography (ICGA), which shows a branching vascular network with aneurysmal dilations.1
While PCV was previously believed to be relatively uncommon in White populations, recent ICGA studies using scanning laser ophthalmoscopy have shown a prevalence of PCV in exudative AMD in White patients as high as 20% to 30%.2 However, PCV is more commonplace among Asian individuals, with up to 50% of exudative AMD related to the PCV subtype.1 The following case report describes a patient of advanced age (99 years) with unilateral, predominantly classic CNV due to the PCV subtype of neovascular AMD. Despite monthly anti-vascular endothelial growth factor (anti-VEGF) injections, the patient continued to show persistent macular edema, intraretinal cysts, retinal pigment epithelial detachment (RPED), and vascular leakage. After undergoing photodynamic therapy (PDT) with VISUDYNE® (verteporfin for injection), the patient’s edema, intraretinal cysts, vascular leakage, and RPED all resolved, with improved visual function. This patient’s anti-VEGF treatment was ongoing with an interval of every 3 months post PDT.
Watch the three videos of Dr. Kokame's Case Study
Case Report: Photodynamic Therapy With VISUDYNE® in a Patient of Advanced Age With Predominantly Classic CNV Due to the PCV Subtype of Neovascular AMD
BACKGROUND: A 99-year-old Asian male presented to my practice reporting decreasing vision in his right eye over the past week. The patient’s visual acuity was 20/40.
Indication
VISUDYNE® (verteporfin for injection) therapy is a photoenhancer indicated for the treatment of patients with predominantly classic subfoveal choroidal neovascularization (CNV) due to age-related macular degeneration, pathologic myopia or presumed ocular histoplasmosis. There is insufficient evidence to indicate VISUDYNE for the treatment of predominantly occult subfoveal CNV.
Important Safety Information
- VISUDYNE® (verteporfin for injection) is contraindicated for patients with porphyria or known hypersensitivity to any component of this preparation.
Please see additional Important Safety Information throughout and full Prescribing Information here.
INITIAL DIAGNOSIS: On fundus photography, temporal subretinal exudates and hemorrhages with RPED were evident (Figure 1A). Spectral-domain optical coherence tomography (SD-OCT) revealed the presence of subretinal fluid with temporal exudates, macular cystic changes, and temporal RPED (Figure 1B). Subretinal hyperreflective material (SHRM) of unknown clinical significance was also observed (Figure 1B). On FA, vascular leakage and vascularized RPED were confirmed (Figure 1C). Further examination of the FA also revealed a temporal blocking defect due to subretinal hemorrhage (Figure 1C). Based on these imaging findings, the patient was diagnosed with neovascular AMD.

Figure 1. Imaging findings at initial presentation. (A) Fundus photography shows temporal subretinal exudates, subretinal hemorrhage, and temporal RPED. (B) SD-OCT shows subretinal fluid, SHRM, temporal RPED, macular cystic changes, and temporal exudates. (C) FA shows vascular leakage, vascular RPED, and a temporal blocking defect due to subretinal hemorrhage.
INITIAL TREATMENT AND REVISION TO DIAGNOSIS: The patient began anti-VEGF therapy with a series of 6 intravitreal aflibercept injections spaced 5 weeks apart. After this series of injections, the patient continued to show evidence of recurrent disease activity and visual acuity had worsened to 20/60. The patient was considering discontinuation of all therapy due to the need for frequent injections with persistent disease activity. On SD-OCT, recurrent macular edema and cystic changes were observed along with a decrease in SHRM (Figure 2A). On FA, the patient showed early hyperfluorescence with profuse late leakage (Figure 2B), consistent with predominantly classic CNV.1
Because the patient’s disease was anti-VEGF-resistant and PCV was suspected, ICGA imaging with the scanning laser ophthalmoscope was performed to probe for the presence of a branching vascular network and/or polypoidal lesions, characteristic of PCV.3,4 ICGA revealed a definitive PCV complex with clearly defined polypoidal dilations (Figure 2C).

Figure 2. Imaging findings after six aflibercept injections spaced 5 weeks apart. (A) SD-OCT shows recurrent macular edema and cystic changes with a reduction in SHRM. (B) FA shows early hyperfluorescence with profuse late leakage, consistent with predominantly classic CNV. (C) ICGA shows a PCV complex with polypoidal dilations.
Based on these updated imaging findings, the patient’s diagnosis was revised to predominantly classic CNV due to the PCV subtype of neovascular AMD.
Important Safety Information (cont.)
- Standard precautions should be taken during infusion of VISUDYNE to avoid extravasation, including but not limited to:
- A free-flowing intravenous (IV) line should be established before starting VISUDYNE infusion and the line should be carefully monitored.
- Due to the possibly fragility of vein walls of some elderly patients, it is strongly recommended that the largest arm vein possible, preferably the antecubital, be used for injection.
- Small veins in the back of the hand should be avoided.
- Extravasation of VISUDYNE, especially if the affected area is exposed to light, can cause severe pain, inflammation, swelling or discoloration at the injection site. Necrosis at the injection site following extravasation has been reported. If extravasation does occur, the infusion should be stopped immediately. The extravasation area must be thoroughly protected from direct light until swelling and discoloration have faded in order to prevent the occurrence of local burn, which could be severe. Cold compresses should be applied to the injection site. Oral medication for pain relief may be administered.
Please see additional Important Safety Information throughout and full Prescribing Information here.
UPDATED TREATMENT PLAN: Because the patient’s disease was refractory to anti-VEGF therapy, which is more common in the PCV subtype of exudative macular degeneration,4 he was recommended for PDT with VISUDYNE® and intravitreal injections of an anti-VEGF agent and a corticosteroid. VISUDYNE therapy is indicated for the treatment of patients with predominantly classic subfoveal CNV due to AMD, pathologic myopia, or presumed ocular histoplasmosis.5 Because the greatest linear dimension of the patient’s PCV complex on ICGA was 2434 µm, PDT was performed using a laser beam diameter of 2800 µm. The PDT procedure was performed at full fluence and guided by ICGA to precisely target the PCV complex. An intravitreal bevacizumab injection and intravitreal dexamethasone injection were administered on the same day after the PDT procedure.
One month after PDT with VISUDYNE, SD-OCT demonstrated that the patient’s macular edema and intraretinal cysts had begun to resolve (Figure 3A). FA revealed a marked decrease in vascular leakage, which was most noticeable in the superior aspect of the macula (Figure 3B). Despite improving retinal anatomy, the patient’s visual acuity had worsened to 20/80. However, 3 months after combining PDT with VISUDYNE, SD-OCT demonstrated complete resolution of macular edema and cystic changes with improvement of the RPED (Figure 4), and the patient’s visual acuity had improved from 20/80 to 20/30. Vision has been stable for 3.5 years with intravitreal injections now limited to every 3 months.

Figure 3. Imaging findings 1 month after PDT with VISUDYNE. (A) SD-OCT shows partially resolved macular edema and cysts. (B) FA shows a marked decrease in vascular leakage, especially superiorly.

Figure 4. SD-OCT findings 3 months after PDT with VISUDYNE. SD-OCT shows fully resolved edema and no cysts.
WHY VISUDYNE®?
Although anti-VEGF therapy remains the standard of care for predominantly classic CNV due to neovascular AMD,6 this patient showed evidence of persistent retinal fluid and worsening vision despite monthly intravitreal aflibercept injections. This recurrent disease activity was attributed to the presence of PCV, which was identified using ICGA to visualize the polypoidal vascular dilations that comprised his PCV complex.
In VISUDYNE therapy, light activation of verteporfin results in local damage to the neovascular endothelium, resulting in vessel occlusion.5 Damaged endothelium is known to release procoagulant and vasoactive factors through the lipoxygenase (leukotriene) and cyclo-oxygenase (eicosanoids such as thromboxane) pathways, resulting in platelet aggregation, fibrin clot formation, and vasoconstriction.5 This mechanism of action provided a means to ablate the PCV complex in this patient, allowing his persistent retinal fluid and vascular leakage to resolve. Outcomes of multiple randomized clinical trials support the use of PDT with VISUDYNE in anti-VEGF-experienced patients with predominantly classic CNV due to the PCV subtype of neovascular AMD.7-9
Important Safety Information (cont.)
- Following injection with VISUDYNE, care should be taken to avoid exposure of skin or eyes to direct sunlight or bright indoor light for 5 days. If emergency surgery is necessary within 48 hours after treatment, as much of the internal tissue as possible should be protected from intense light.
- Patients who experience severe decrease of vision of 4 lines or more within 1 week after treatment should not be retreated, at least until their vision completely recovers to pretreatment levels and potential benefits and risks of subsequent treatment are carefully considered by the treating physician.
Please see additional Important Safety Information throughout and full Prescribing Information here.
FOLLOW-UP: Three years after PDT with VISUDYNE®, the patient was on a regimen of intravitreal aflibercept injections spaced 3 months apart. Visual acuity was 20/60 at the start of intravitreal aflibercept therapy and had improved to 20/30 at the patient’s most recent visit to my practice. On SD-OCT, the patient continued to show absence of macular edema and intraretinal cysts, with no evidence of new or recurring disease activity (Figure 5).
Figure 5. SD-OCT findings 3 years after PDT with VISUDYNE and after initiation of intravitreal aflibercept injections every 3 months. SD-OCT shows continuation of fully resolved edema and no cysts.
CONCLUSIONS
PCV is a subtype of neovascular AMD characterized by dilated polypoidal aneurysmal lesions and/or a branching vascular network on ICGA,1,3,4 although recent data have demonstrated that U-shaped elevated lesions on the OCT B-scan may be helpful for identification of PCV without ICGA.10 PCV is common among Asian individuals with neovascular AMD, but it may be more common in White populations than previously recognized (~30% of neovascular AMD cases).2 PCV is also more likely to be anti-VEGF-resistant than conventional neovascular AMD,2 which emphasizes the importance of considering alternative treatment approaches, such as combining anti-VEGF therapy with PDT.11
This case involved a 99-year-old patient with unilateral, predominantly classic CNV due to neovascular AMD that was resistant to monthly intravitreal aflibercept injections. ICGA imaging identified a PCV complex in this patient, which was composed of well-defined polypoidal dilations. PDT with VISUDYNE was used to ablate the PCV complex, allowing resolution of macular edema and intraretinal cysts within 3 months. In the long term, the patient’s anti-VEGF burden was reduced to an aflibercept injection every 3 months. This case demonstrates the utility of PDT with VISUDYNE for anti-VEGF-experienced patients with predominantly classic CNV due to the PCV subtype of neovascular AMD. This utility is supported by the outcomes of several randomized clinical trials.7-9
Important Safety Information (cont.)
- Cases of anaphylactic reactions have been reported. Immediately discontinue VISUDYNE and initiate appropriate therapy if anaphylactic or other serious allergic reactions occur during or following therapy.
- The most frequently reported adverse events (occurring in approximately 10%-30% of patients) were injection site reactions (including pain, edema, inflammation, extravasation, rashes, hemorrhage, and discoloration), and visual disturbances (including blurred vision, flashes of light, decreased visual acuity, and visual field defects, including scotoma).
You are encouraged to report negative side effects of prescription drugs to the FDA. Visit www.fda.gov/medwatch or call 1-800-FDA-1088.
Please see additional Important Safety Information throughout and full Prescribing Information here.
1. Spaide RF, Jaffe GJ, Sarraf D, et al. Consensus nomenclature for reporting neovascular age-related macular degeneration data: Consensus on Neovascular Age-Related Macular Degeneration Nomenclature study group. Ophthalmology. 2020;127(5):616-636.
2. Kokame GT, deCarlo TE, Kaneko KN, Omizo JN, Lian R. Anti-vascular endothelial growth factor resistance in exudative macular degeneration and polypoidal choroidal vasculopathy. Ophthalmol Retina. 2019;3(9):744-752.
3. Fenner BJ, Cheung CMG, Sim SS, et al. Evolving treatment paradigms for PCV. Eye (Lond). 2022;36(2):257-265.
4. Cheung CMG, Lai TYY, Teo K, et al. Polypoidal choroidal vasculopathy: consensus nomenclature and non-indocyanine green angiograph diagnostic criteria from the Asia-Pacific Ocular Imaging Society PCV Workgroup. Ophthalmology. 2021;128(3):443-452.
5. VISUDYNE Prescribing Information. Bausch & Lomb Incorporated.
6. Lanzetta P, Loewenstein A; Vision Academy Steering Committee. Fundamental principles of an anti-VEGF treatment regimen: optimal application of intravitreal anti-vascular endothelial growth factor therapy of macular diseases. Graefes Arch Clin Exp Ophthalmol. 2017;255(7):1259-1273.
7. Koh A, Lee WK, Chen LJ, et al. EVEREST study: efficacy and safety of verteporfin photodynamic therapy in combination with ranibizumab or alone versus ranibizumab monotherapy in patients with symptomatic macular polypoidal choroidal vasculopathy. Retina. 2012;32(8):1453-1464.
8. Koh A, Lai TYY, Takahashi K, et al. Efficacy and safety of ranibizumab with or without verteporfin photodynamic therapy for polypoidal choroidal vasculopathy: a randomized clinical trial. JAMA Ophthalmol. 2017;135(11):1206-1213.
9. Lim TH, Lai TYY, Takahashi K, et al. Comparison of ranibizumab with or without verteporfin photodynamic therapy for polypoidal choroidal vasculopathy: the EVEREST II randomized clinical trial. JAMA Ophthalmol. 2020;138(9):935-942.
10. Kokame GT, Omizo JN, Kokame KA, Yamane ML. Differentiating exudative macular degeneration and polypoidal choroidal vasculopathy using OCT B-scan. Ophthalmol Retina. 2021;5(10):954-961.
11. Kokame GT, Kim JE. Treatment for a subtype of exudative macular degeneration—another mountain climbed. JAMA Ophthalmol. 2020;138(9):942-944.
VISUDYNE is a registered trademark of Cheplapharm Arzneimittel GmbH used under license.
©2023 Bausch + Lomb.
VID.0026.USA.23

